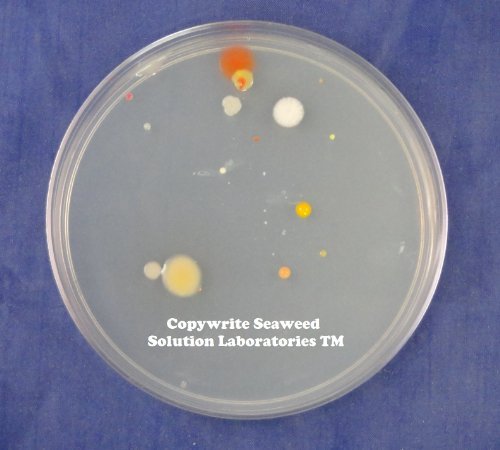
Thumbnail 2
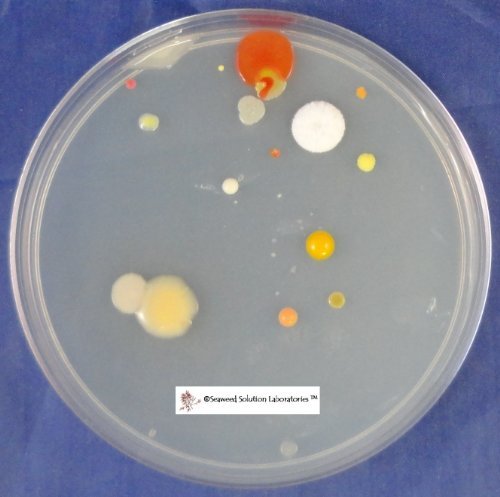
Thumbnail 3

Customer Services
Copyright © 2025 Desertcart Holdings Limited

🧫 Elevate your experiments with lab-grade precision and unbeatable yield!
This 350ml sterile nutrient agar provides a high-quality, lab-grade medium that yields 14-16 standard 100mm petri dishes, ensuring contamination-free, consistent results for all your microbiological and scientific experiments.
Trustpilot
3 weeks ago
3 weeks ago
2 months ago
4 days ago